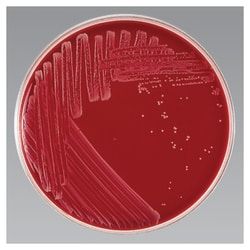

R01562
Thermo Scientific™ MacConkey Agar Medium
Manufacturer: Fischer Scientific
The price for this product is unavailable. Please request a quote
Certifications/Compliance
Industrial Reference: BAM, COMPF, SMWW, USP.
Manufacturing Origin
United States
Product Type
Agar
Format
10mm x 100mm Spacesaver Plate
Media Type
MacConkey Agar
Quantity
150/Pk.
Description
- Detect and enumerate coliform organisms, including E
- coli , while isolating and detecting Salmonella and Shigella spp
- in both pathological and food specimens using Thermo Scientific™ MacConkey Agar
- Urinary tract infections, bacteremia, meningitis, and diarrheal disease are the most frequent clinical syndromes associated with Escherichia coli
- Escherichia coli O157:H7 is associated with hemorrhagic colitis and hemolytic-uremic syndrome (HUS)
- Escherichia coli is an aerobic, gram-negative bacillus most frequently isolated from the intestines of humans and animals
- As a result, it is used as an indicator of fecal contamination in water sources
- This pathogen readily grows on a variety of culture media including MacConkey Agar
- Salmonella and Shigella are major causes of bacterial enteric illness
- Transmission occurs via the fecal-oral route, person-to-person contact, or by the ingestion of contaminated food or water
- A relatively small number of organisms ingested is capable of causing symptomatic infection
- While multidrug resistant Shigellae are prevalent, a multidrug resistant strain of Salmonella typhimurium (DT104) emerged in 1985 that is resistant to five antibiotics
- Salmonella and Shigella are aerobic, gram-negative, oxidase-negative bacilli
- Some Salmonella and all Shigella are nonmotile
- These organisms grow on standard media, such as MacConkey Agar, SS Agar, and XLD Agar
- Enrichment broths should also be used when culturing for these organisms to allow for maximum recovery
- Not all products are available for sale in all territories
- Please inquire
- Remel™ and Oxoid™ products are now part of the Thermo Scientific brand, combining powerful manual, semi-automated and fully automated test products and a comprehensive line of media and diagnostic products to offer a complete, end-to-end solution to quickly deliver the products you need and the quality results your laboratory depends on.